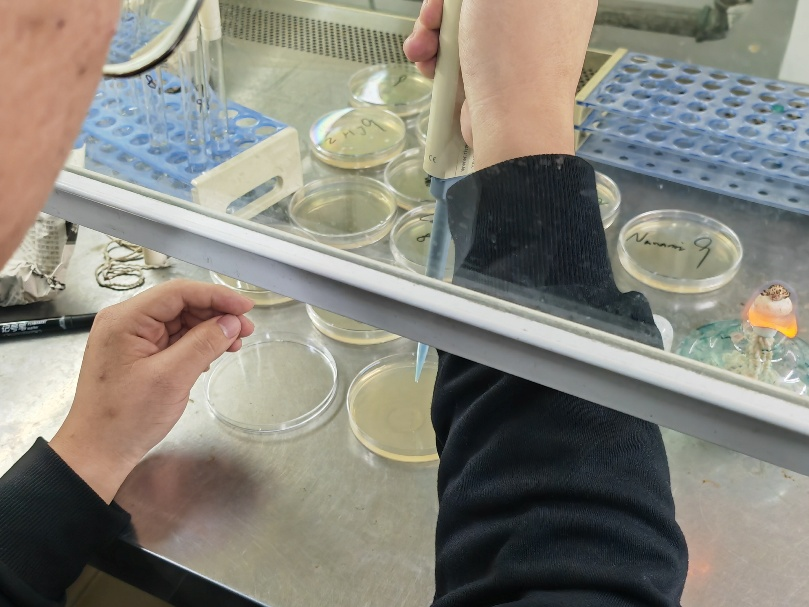

发布时间:2025/10/15 17:27:52 作者:郭益彤
10月13日,一场紧张有序的生命科学探索之旅在河南大学生命科学学院基础教育实验室圆满落幕。河南省开封高级中学2617、2618班的部分学生在史静娟、王丹亚老师的带领下,利用课余时间赴河南大学进行了包括DNA提取、扩增、电泳、微生物培养和植物组织培养的一系列实验,在实践中收获了知识、技能与满满的科研热情,用严谨细致的操作和积极求索的态度,生动诠释了开高学子的卓越风采。
首先,河南大学生命科学学院的郜晓峰教授围绕实验器材消毒方法、原理、酵母菌培养基的配制方法以及各种菌种的培养方法开展专题讲解,为学生们筑牢理论基础。讲解完毕之后,老师先行为大家演示实验仪器的使用方法和各种实验操作,随后,同学们分组投入实操环节。同学们严格遵循无菌操作,精确称量各种成分配制培养基,在高压蒸汽灭菌后,小心翼翼地在超净工作台前进行倒平板。待培养基凝固后,每位同学都分别用涂布器和接种环尝试了几种枯草芽孢杆菌的接种方法。从生疏到熟练,学生们对于课本上相关知识的理解也愈发深刻。




随后,苏亚蕊教授为大家细致讲解了植物组织培养实验的实验原理及具体操作方法。学生们大家以西瓜种子为材料。先对种子进行严格的消毒处理,再在无菌条件下将其接种到培养基上。学生们每一个动作都轻柔而精准,同时也对无菌操作的概念和具体操作方法有了更加实际的学习,对于无菌培养的知识点理解更加透彻。


在分子生物学实验中,董薇教授首先为大家进行了分子生物学实验原理与实验步骤的详细讲解,之后为大家演示了离心机、PCR仪、电泳仪等仪器的使用方法。学生们将西瓜幼苗在液氮中进行研磨来提取DNA,再加入各种试剂进行PCR扩增,最后将扩增产物进行琼脂凝胶电泳。当在紫外灯下看到清晰明亮的DNA条带时,同学们脸上都露出了成功的喜悦,真切感受到了科研的魅力。





从理论学习至动手实践,同学们全程专注投入,不仅顺利完成所有实验,更收获了高纯度DNA样品及规范的电泳条带等优秀成果。实验过程中,大家互相协作、细致观察、及时记录,遇到问题主动向老师请教,将课堂所学转化为实践能力,充分展现了开高学子扎实的知识功底、严谨的科学素养和积极探索的精神。此次研学活动搭建起高中教育与高等教育的衔接桥梁,让学生们直观触摸生命科学的前沿脉搏。未来,开封市高级中学将持续推进实践育人,助力更多学子在科学探索的道路上扬帆起航。(摄影:郭益彤 一审(校):史静娟 二审(校):毛广文 三审(校):张志强)
发布时间:2025/10/15 17:27:52 作者:郭益彤
10月13日,一场紧张有序的生命科学探索之旅在河南大学生命科学学院基础教育实验室圆满落幕。河南省开封高级中学2617、2618班的部分学生在史静娟、王丹亚老师的带领下,利用课余时间赴河南大学进行了包括DNA提取、扩增、电泳、微生物培养和植物组织培养的一系列实验,在实践中收获了知识、技能与满满的科研热情,用严谨细致的操作和积极求索的态度,生动诠释了开高学子的卓越风采。
首先,河南大学生命科学学院的郜晓峰教授围绕实验器材消毒方法、原理、酵母菌培养基的配制方法以及各种菌种的培养方法开展专题讲解,为学生们筑牢理论基础。讲解完毕之后,老师先行为大家演示实验仪器的使用方法和各种实验操作,随后,同学们分组投入实操环节。同学们严格遵循无菌操作,精确称量各种成分配制培养基,在高压蒸汽灭菌后,小心翼翼地在超净工作台前进行倒平板。待培养基凝固后,每位同学都分别用涂布器和接种环尝试了几种枯草芽孢杆菌的接种方法。从生疏到熟练,学生们对于课本上相关知识的理解也愈发深刻。

随后,苏亚蕊教授为大家细致讲解了植物组织培养实验的实验原理及具体操作方法。学生们大家以西瓜种子为材料。先对种子进行严格的消毒处理,再在无菌条件下将其接种到培养基上。学生们每一个动作都轻柔而精准,同时也对无菌操作的概念和具体操作方法有了更加实际的学习,对于无菌培养的知识点理解更加透彻。


在分子生物学实验中,董薇教授首先为大家进行了分子生物学实验原理与实验步骤的详细讲解,之后为大家演示了离心机、PCR仪、电泳仪等仪器的使用方法。学生们将西瓜幼苗在液氮中进行研磨来提取DNA,再加入各种试剂进行PCR扩增,最后将扩增产物进行琼脂凝胶电泳。当在紫外灯下看到清晰明亮的DNA条带时,同学们脸上都露出了成功的喜悦,真切感受到了科研的魅力。





从理论学习至动手实践,同学们全程专注投入,不仅顺利完成所有实验,更收获了高纯度DNA样品及规范的电泳条带等优秀成果。实验过程中,大家互相协作、细致观察、及时记录,遇到问题主动向老师请教,将课堂所学转化为实践能力,充分展现了开高学子扎实的知识功底、严谨的科学素养和积极探索的精神。此次研学活动搭建起高中教育与高等教育的衔接桥梁,让学生们直观触摸生命科学的前沿脉搏。未来,开封市高级中学将持续推进实践育人,助力更多学子在科学探索的道路上扬帆起航。(摄影:郭益彤 一审(校):史静娟 二审(校):毛广文 三审(校):张志强)